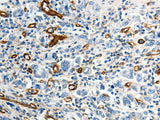
ABCG1 Polyclonal Antibody Store at -20°C

ABCG1 Polyclonal Antibody Store at -20°C
SKU: E-AB-12687-200
ABCG1 Polyclonal Antibody Store at -20°C
| SKU # | E-AB-12687 |
| Reactivity | Human |
| Host | Rabbit |
| Applications | WB, IHC |
Product Details
| Isotype | IgG |
| Host | Rabbit |
| Reactivity | Human |
| Applications | WB, IHC |
| Clonality | Polyclonal |
| Immunogen | Synthetic peptide of human ABCG1 |
| Abbre | ABCG1 |
| Synonyms | ABC transporter 8, ABC8, ABCG1, ATP-binding cassette, ATP-binding cassette sub family G member 1, ATP-binding cassette sub-family G member 1, ATP-binding cassette transporter 8, ATP-binding cassette transporter member 1 of subfamily G, sub family G WHITE me |
| Swissprot | |
| Calculated MW | 76 kDa |
| Cellular Localization | Endoplasmic reticulum membrane. Golgi apparatus membrane. Predominantly localized in the intracellular compartments mainly associated with the endoplasmic reticulum (ER) and Golgi membranes. |
| Concentration | 0.2 mg/mL |
| Buffer | Phosphate buffered solution, pH 7.4, containing 0.05% stabilizer and 50% glycerol. |
| Purification Method | Affinity purification |
| Research Areas | Cancer, Cardiovascular, Metabolism, Neuroscience, Signal Transduction |
| Conjugation | Unconjugated |
| Storage | Store at -20°C Valid for 12 months. Avoid freeze / thaw cycles. |
| Shipping | The product is shipped with ice pack,upon receipt,store it immediately at the temperature recommended. |
Related Reagents
| Applications | Recommended Dilution |
| WB | 1:500-1:2000 |
| IHC | 1:25-1:100 |
Background
The protein encoded by this gene is a member of the superfamily of ATP-binding cassette (ABC) transporters. ABC proteins transport various molecules across extra- and intra-cellular membranes. ABC genes are divided into seven distinct subfamilies (ABC1, MDR/TAP, MRP, ALD, OABP, GCN20, White). This protein is a member of the White subfamily. It is involved in macrophage cholesterol and phospholipids transport, and may regulate cellular lipid homeostasis in other cell types. Six alternative splice variants have been identified.